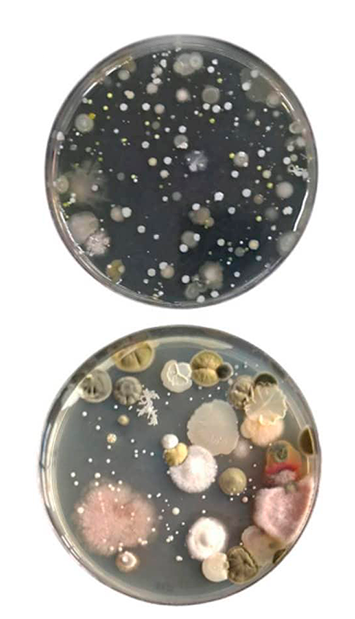
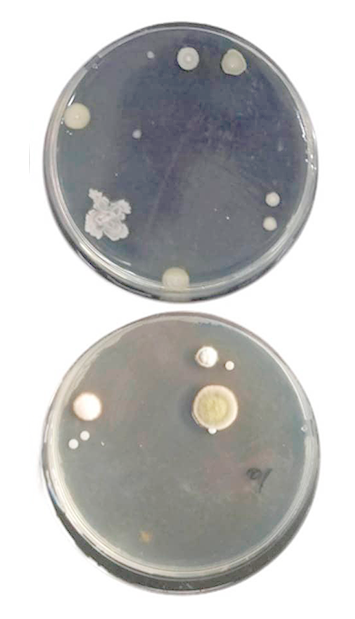

Proteja você e sua família.
Estamos aqui para ajudar você a ter sua casa livre de fungos, ácaros e realçar e beleza de sua sala.
Porque fazer a limpeza dos estofados é importante?
Assim como todos os móveis da casa, o estofado também precisa de cuidados para ser preservado por mais tempo e evitar doenças respiratórias. Doenças como sinusite, rinite alérgica e asma podem surgir através do acúmulo de poeira, ácaros, umidade e demais tipos de sujeiras que acumulam nos estofados. Além de evitar problemas de saúde, um estofado limpo da um charme em qualquer decoração. Então já fica sabendo da importância de manter tudo sempre limpo e higienizado, para evitar problemas futuros.

A Nit Clean é uma empresa de excelência no ramo de limpeza e impermeabilização, que atua no mercado desde 2018 com o objetivo de trazer a plena satisfação de seus clientes.
E para que isto se concretize contamos com uma equipe especializada, além de equipamentos e utensílios do que é mais moderno no mercado nacional e internacional.
Mantendo e aperfeiçoando esse princípio, a Nit Clean exerce uma postura de seriedade, eficiência em busca da excelência no relacionamento com seus clientes, aplicando constantes treinamentos à sua equipe.
A limpeza dos estofados é 100% Segura!

Nos preocupamos com seu bem estar e por isso sempre estamos atualizados com os melhores produtos do mercado!
Quando feita por pessoas não qualificadas, a Limpeza de Sofá pode se tornar algo extremamente desagradável, demorado e perigoso, pois ainda existem profissionais que utilizam produtos inflamáveis dentro da sua casa.
Pensando no conforto e na segurança da sua família, nosso processo de limpeza, utiliza apenas produtos aprovados pela ANVISA, não inflamáveis, de baixo odor e rápido poder de ação.
Entenda o processo
Entenda o Processo da nossa Limpeza desenvolvido 100% pensado na sua segurança e satisfação!
Desacarizacão: Retirada de toda poeira fina, fungos e ácaros do tecido e da espuma de seu estofado. Associado a esse processo realizamos a aspiração de todo estofado (laterais, costas, cantos e fundo do sofá)
Aplicação de Produtos Biodegradáveis e Dermatologicamente testados em todo sofá: Dependendo do grau de sujidade, da característica do tecido ou do problema encontrado pelo técnico podemos utilizar até 4 produtos. Lembrando que nossos produtos não trazem risco para o tecido, piso e animais de estimação.
Esfregação manual: Utilizando escovas com cerdas próprias para cada tipo de tecido, a fim de não danificá-lo. O produto é retirado com uma extratora que remove também as impurezas e toda a sujeira, assim como os ácaros que se acumulam na superfície do tecido.
Secagem final: com nossos secadores B-air. Adiantamos a secagem para que de 2 a 4 horas após o serviço você já possa utilizar seus estofados.






Entre em contato conosco e faça já seu orçamento para melhorar sua qualidade de vida !

Página desenvolvida por: Agência MSD